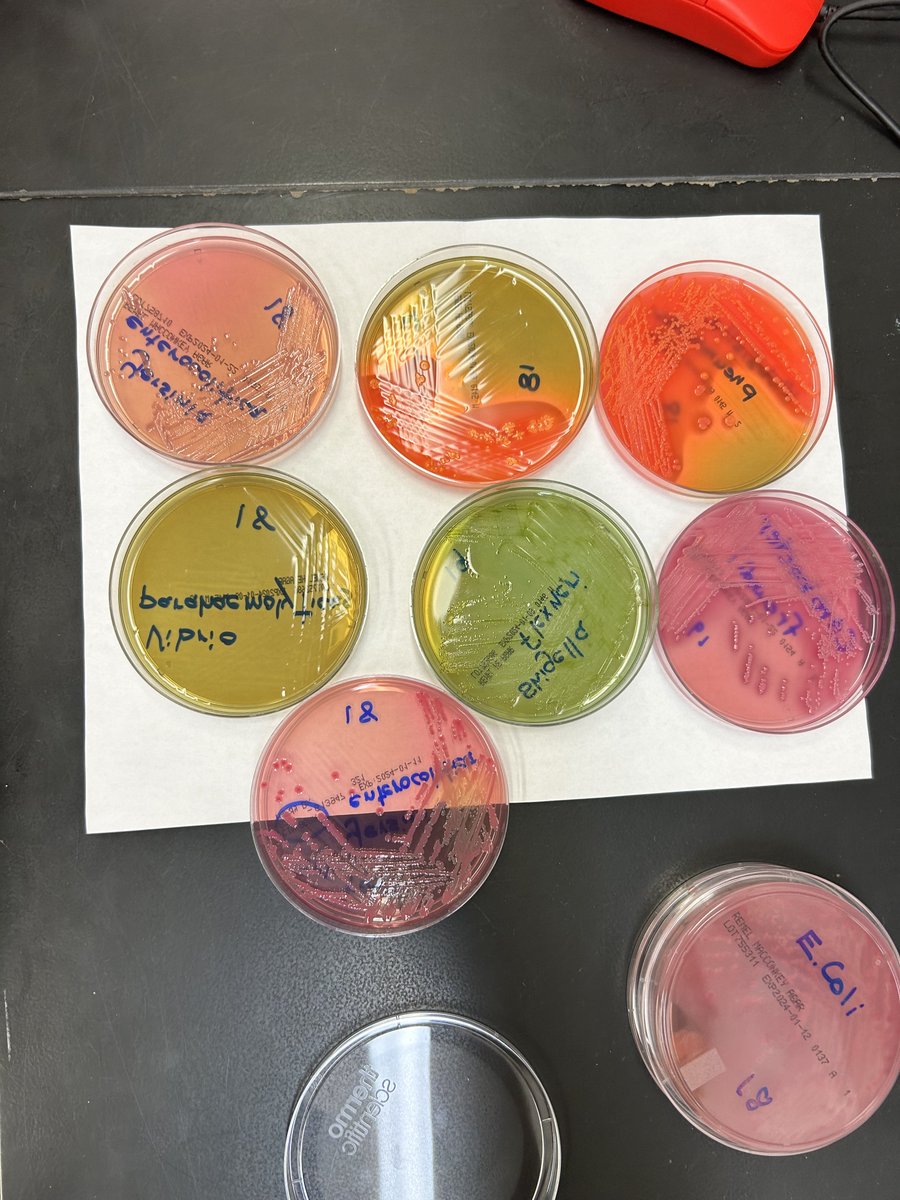
Wayne State ID Fellowship tweet media

고정된 트윗

We are looking to fill our two vacant ID fellowship spots at DMC/Wayne State University, Detroit . Interested candidates please contact our PD Dr Sorabh Dhar at sdhar@med.wayne.edu or our APD @DrMondayMD or our program co-ordinator Carmen McIntosh at cmcintosh@med.wayne.edu


English